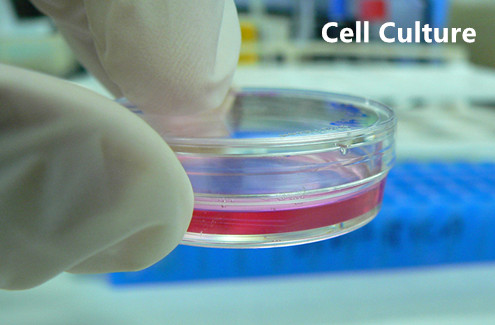

-
 2021-09-23Precautions, maintenance and repair to spring testing machine.More >
2021-09-23Precautions, maintenance and repair to spring testing machine.More > -
 2021-08-13What are the advantages, applications of jacketed glass reactors?More >
2021-08-13What are the advantages, applications of jacketed glass reactors?More > -
.jpg) 2021-08-01The troubleshooting of double-layer glass reactorMore >
2021-08-01The troubleshooting of double-layer glass reactorMore > -
 2021-07-22Methods and classification of instrumental analysisMore >
2021-07-22Methods and classification of instrumental analysisMore > -
 2021-07-05How do you test a button tension?More >
2021-07-05How do you test a button tension?More > -
 2021-06-30Application of molecular distillation apparatus in fine chemistry.More >
2021-06-30Application of molecular distillation apparatus in fine chemistry.More > -
 2021-06-08How to extend the service life of electronic balance?More >
2021-06-08How to extend the service life of electronic balance?More > -
2021-05-25Advantages of parallel bioreactors in cell culture applications.More >
2021-05-25Advantages of parallel bioreactors in cell culture applications.More > -
 2021-05-09All you need to know about CO2 incubator(2)More >
2021-05-09All you need to know about CO2 incubator(2)More >

